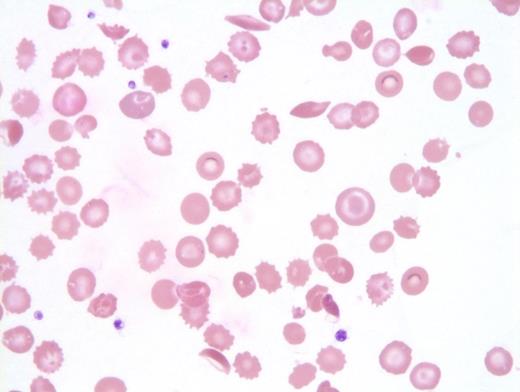
Abnormal red cell findings in peripheral blood.

A 73-year-old woman with a long-standing history of anemia for which she received intravenous iron infusions, and a history of clinically significant antibody (anti-E), was transfused one unit of matched pRBC in the emergency department for dizziness and anemia with borderline microcytosis (hemoglobin, 6.9 g/dL; mean corpuscular volume, 80.7 fL). The patient also had a history of heart failure and chronic kidney disease. She was admitted approximately one week later with chest pain and was found to have an elevated pro–B-type natriuretic peptide and high-sensitivity troponin. Her hemoglobin subsequently dropped from 8.5 g/dL to 6.9 g/dL, lactate dehydrogenase was elevated (1,209 U/L), and haptoglobin was undetectable (<20 mg/dL). A transfusion reaction evaluation was ordered. No new clinically significant antibodies were detected, direct antiglobulin test (DAT) was negative, and (out of an abundance of caution) an eluate was performed that was negative as well. The patient received ongoing transfusion support and had worsening renal failure and decompensated heart failure.
The patient’s mental status waxed and waned, and ferritin was above the quantifiable range (>100,000 ng/mL). Triglycerides were only mildly elevated, fibrinogen was elevated, and D-dimer was significantly elevated. There was some clinical suspicion for hemophagocytic lymphohistiocytosis (HLH), so a bone marrow biopsy was performed. Complete blood count results on the day of biopsy were as follows:
| Value | |
| White blood cells | 12.3×109/L |
| Red blood cells | 2.43×1012/L |
| Hemoglobin | 6.9 g/dL |
| Mean corpuscular volume | 76.1 fL |
| Mean corpuscular hemoglobin | 28.4 pg |
| Mean corpuscular hemoglobin concentration | 37.3 g/dL |
| Red cell distribution width | 16.3% |
| Platelet count | 102×109/L |
| Absolute neutrophil count | 8.93×109/L |
| Value | |
| White blood cells | 12.3×109/L |
| Red blood cells | 2.43×1012/L |
| Hemoglobin | 6.9 g/dL |
| Mean corpuscular volume | 76.1 fL |
| Mean corpuscular hemoglobin | 28.4 pg |
| Mean corpuscular hemoglobin concentration | 37.3 g/dL |
| Red cell distribution width | 16.3% |
| Platelet count | 102×109/L |
| Absolute neutrophil count | 8.93×109/L |
Peripheral blood showed abnormal red cell findings (Figure 1) with erythroblastosis (not shown). Aspirate showed trilineage hematopoiesis with erythroid predominance (Figure 2). Core biopsy showed hypercellular marrow (Figures 3 and 4) with focal areas of marrow damage (Figure 5). Hemoglobin high-performance liquid chromatography (HPLC) was performed (Figure 6).
A. Pure erythroid leukemia
B. Hemoglobin SS disease
C. Hemoglobin SC disease
D. Delayed hemolytic transfusion reaction
Sorry, that was not the preferred response.
Correct!
The peripheral blood showed numerous target cells, burr cells, and microcytes, as well as partially sickled cells and blister-like cells. Core biopsy shows erythroid hyperplasia with large clusters of sickled cells (present in macrophages by CD68 stain; not shown).
HPLC performed on a peripheral blood sample after the bone marrow biopsy showed significant amounts of hemoglobin S (19.1%) and hemoglobin C (17.8%) variants. The amount of hemoglobin A likely represents donor transfused blood. These findings are consistent with hemoglobin SC disease in a recently multiply transfused patient. The presence of greater than 10 percent hemoglobin C is typically not compatible with transfusion and implies congenital hemoglobin C trait or disease.1 Therefore, this patient cannot have hemoglobin SS disease based on the HPLC curve. Additionally, if the patient had hemoglobin SS disease, we would not expect her to present to medical care at age 73 years without a well-defined history of sickle cell disease (SCD). In fact, her likelihood of living to age 73 years would be significantly reduced because median survival for individuals in the U.S. with hemoglobin SS disease is 58 years (while median survival for patients with hemoglobin SC disease is 66 years).2
The focal areas of bone marrow necrosis are the consequence of ischemic marrow damage caused by vascular obstruction by sickle cells. In a patient with sickle cell variant, multiorgan failure with altered mental status and focal bone marrow necrosis, the findings raise concern for bone marrow necrosis/fat embolism syndrome (BMN/FES).3 BMN/FES is more common in non– hemoglobin SS SCD variants such as hemoglobin SC.4 Brain MRI can show “starfield” on diffusion-weighted MRI in patients with severe neurologic impairment due to emboli.5,6 This patient did not undergo MRI after her decompensation.
The differential diagnosis for BMN/FES includes thrombotic thrombocytopenic purpura (TTP), HLH, and hyperhemolysis. That this patient’s platelet count was well above 30 × 109/L as well as an ADAMTS13 level of 61 percent ruled out TTP. The bone marrow was originally performed to investigate for HLH (given the markedly elevated ferritin). There were numerous hemophagocytic macrophages with engulfed sickle cells (confirmed by CD68 stain). However, this finding can be seen in the setting of sickle crisis without being associated with HLH disease. Aspirate smear and touch prep did not reveal prominent hemophagocytic macrophages as are typically seen in HLH. The presence of erythroblastosis also argues against HLH.
In a recently transfused patient with sickle cell variant, the presence of worsening hemolytic anemia also raises the possibility of delayed transfusion reaction (DHTR). For this patient, DAT was only either negative or weakly positive, and the patient’s eluate remained negative. These findings argue against DHTR. Hyperhemolysis is another consideration because it is characterized by more severe hemolysis than DHTR, with both donor and recipient red cells being hemolyzed; hence, there is a decrease in hemoglobin to below pretransfusion levels, which is often associated with a reticulocytopenia and a negative DAT.7 This patient met all of these criteria. She rapidly hemolyzed four units of pRBC before additional diagnosis of hyperhemolysis was made and transfusions were withheld.
The presence of blister cells and low G6PD activity (hemoglobin, 4.7 U/g; reference range, 8.8-13.4 U/ g) also argues for a component of oxidative damage causing ongoing hemolysis for this patient.While there is an erythroid expansion with left shift (and pronormoblasts present), there is trilineage hematopoiesis with maturation. Pronormoblasts are not greater than 30 percent of cellularity. Therefore, this case does not meet criteria for pure erythroid leukemia.8
In summary, this is a 73-year-old patient with newly diagnosed hemoglobin SC disease and multiorgan failure. Bone marrow showed typical SCD-related changes with the additional finding of BMN. This finding raised the possibility of BMN/FES. The patient also seemed to be rapidly hemolyzing matched packed red blood cell units, consistent with the additional diagnosis of hyperhemolysis. In bone marrow biopsy specimens containing necrosis without morphologically identifiable malignancy or a clinical history of metastatic/hematolymphoid malignancy, a broad differential diagnosis should be considered.9
References
References
Dr. Fidai and Dr. Wool indicated no relevant conflicts of interest.